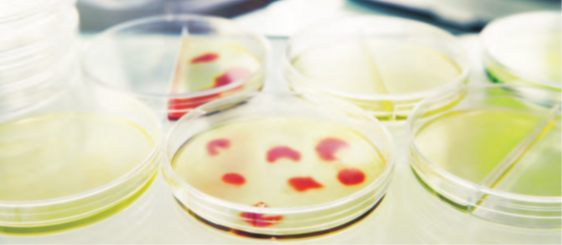
Test

O nama
BIOLINE TEC DOO osnovana je 2017.godine, bavimo se uvozom i distribucijom starter kultura, sirila, testova za kontrolu kvaliteta hrane, testova za površinsku kontrolu higijene, mikrobiološku kontrolu, pomoćnog materijala i pribora za potrebe prehrambene industrije sa posebnim osvrtom na potrebe mlekara.
Naš tim čine diplomirani inženjeri prehrambene tehnologije sa dugogodišnjim radnim iskustvom u mlekarama i drugim prehrambenim industrijama, koji svoje stečeno znanje i iskustvo žele da podele i prenesu našim kupcima.
Osnovni cilj kompanije je da ponudi proizvode visokog kvaliteta po konkurentnim cenama, kao i kvalitetnu stručnu tehničko -tehnološku podršku svojim kupcima pružanjem najboljih rešenja koja zadovoljavaju potrebe kupaca i obezbeđuju najbolji tehnološki i ekonomski rezultat uz stvaranje profesionalnog odnosa prema kupcima zasnovanih na poverenju i pouzdanosti.
Svi proizvodi iz našeg asortimana su proizvedeni pod strogo kontrolisanim uslovima, poseduju tehničke specifikacije, kao i odgovarajuće sertifikate koji dokumentuju njihov kvalitet i garantuju bezbezdnost vaše proizvodnje.